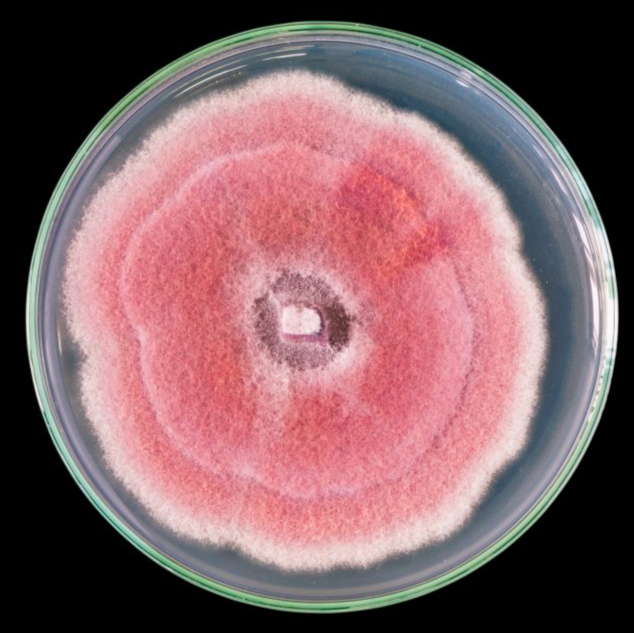
P5ARP/P10ARP Media Preparation

Jul 31, 2023
P5ARP/P10ARP Media Preparation
- 1USDA ARS

Protocol Citation: rebecca.bennett 2023. P5ARP/P10ARP Media Preparation. protocols.io https://dx.doi.org/10.17504/protocols.io.n2bvj361nlk5/v1
License: This is an open access protocol distributed under the terms of the Creative Commons Attribution License, which permits unrestricted use, distribution, and reproduction in any medium, provided the original author and source are credited
Protocol status: Working
We use this protocol and it's working
Created: July 28, 2023
Last Modified: January 31, 2024
Protocol Integer ID: 85663
Keywords: PARP, P5ARP, P10ARP, selective media, Pythium media, inactivation of pimaricin, pimaricin, oospore germination of pythium, antifungal antibiotic, spectrum antifungal antibiotic, p10arp media preparation, pythiaceae, antibiotic, pentachloronitrobenzen, growth of true fungi, pythium, true fungi, ampicillin, phytophthora, most members of the pythiaceae, weeks before antibiotic, rifampicin, oospore germination, p5arp
Disclaimer
DISCLAIMER – FOR INFORMATIONAL PURPOSES ONLY; USE AT YOUR OWN RISK
The protocol content here is for informational purposes only and does not constitute legal, medical, clinical, or safety advice, or otherwise; content added to protocols.io is not peer reviewed and may not have undergone a formal approval of any kind. Information presented in this protocol should not substitute for independent professional judgment, advice, diagnosis, or treatment. Any action you take or refrain from taking using or relying upon the information presented here is strictly at your own risk. You agree that neither the Company nor any of the authors, contributors, administrators, or anyone else associated with protocols.io, can be held responsible for your use of the information contained in or linked to this protocol or any of our Sites/Apps and Services.
Abstract
How to make P5ARP and P10ARP media plates, simplified from https://wiki.bugwood.org/PARP_or_PARP
Contains: pimarcin, ampicillin, rifampicin, pentachloronitrobenzens.
Pimaricin is a broad-spectrum antifungal antibiotic that inhibits the true fungi but not most members of the Pythiaceae. Once in solution, it is inactivated by light so that culture plates must be stored and incubated in the dark. Growth of true fungi indicates the inactivation of pimaricin. Concentrations above 10 mg a.i./liter inhibit oospore germination of Pythium and Phytophthora
Plates will last for 1-1.5 weeks before antibiotics are degraded.
Materials
Difco cornmeal agar
RO
rifampicin
DMSO
microcentrifuge tubes
ampicillin
Delvocid (50% natamycin)
Terraclor 75 WP (wettable powder - see safety notes)
Petri dishes (90 or 60 mm)
Equipment:
1.5 or 2L Erlenmeyer flask
Stir plate and bars
Fine weigh scale
Autoclave and materials
Hot water bath
Biosafety Hood
Ethanol (80%)
1 L media bottles
Safety warnings
Terraclor - May cause sensitization by skin contact. Experimental carcinogen and neoplastigen
Personal Protective Measures: Nitrile Gloves × Adequate Ventilation × Safety Glasses× Dust Mask
Before start
See Safety Warnings.
Preparation
Sign up for Autoclave and turn on.
Add 17 g of Difco cornmeal agar to each 2 L Erlenmeyer flask
Add RO water to 1000 mL line (pre-measure line and mark with sharpie or use a graduated cylinder).
Cover top with foil so that at least 2" of foil is below flask lip.
Add stir bar and mix well over stir plate.
Autoclave media in flask alongside 1 L media bottle (loosely capped), for 20 minutes on liquid cycle.
Turn on hot water bath and set to 50 °C .
Prepare hood by wiping down with 80% EtOH and labeling Petri dishes.
Prepare rifampicin solution: 0.01 g rifampicin dissolved in 1 mL DMSO in a microcentrifuge tube.
Cover tube with foil and keep away from light.
After Sterilization
Check temperature of hot water bath (between 50 °C to 55 °C ).
Place sterilized basal media in hot water bath and wait for temperature to decrease target range. Higher temperatures will inactivate antibiotics!
Fume hood:
Add to each 1 L media bottle (wear gloves, eye protection, and dust mask!) on a stir plate:
0.25 g ampicillin sodium salt
5 mg = 0.005 g Delvocid (50% natamycin)
Note
Use 10 mg (0.01 g ) for P10ARP
10 mg = 0.01 g rifampicin dissolved in 1 mL DMSO
1 g Terraclor WP (wettable powder)
Mix completely.
Plating
Pour half into the sterile 1L media bottle.
Immediately pour into Petri dishes.
Refill with remaining media and dispense into Petri dishes.
Immediately fill empty bottle with tap water when finished so that agar does not dry on glass.
Mark plates with a single red bar using a Sharpie. Attach lab tape with date and your initials to stack of plates.
When agar has solidified (8-24h), place back into sleeves and label bottom outside of bag with date made and your initials.
Store in fridge as soon as possible to preserve the antibiotics.
Wash bottles before media dries.
Protocol references
Jeffers, S.N. and S.B. Martin. 1986. Comparison of two media selective for Phytophthora and Pythium species. Plant Dis. 70:1038–43.
R. Bennett Plant Pathology Lab - USDA ARS
